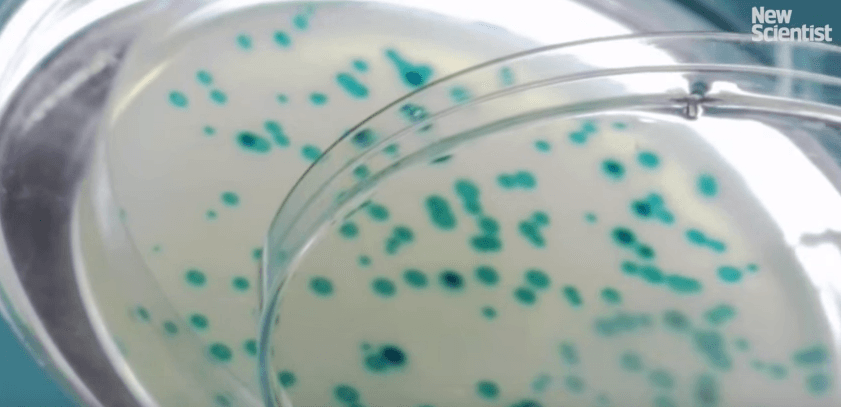

Un equipo de estadounidenses se encuentra trabajando en recodificar la bacteria E.coli para trabajar con un código genético diferente a todos los organismos de la tierra, lo que significa hacer más de 62.000 cambios en su genoma.
Este microbio sintético es resistente a todos los virus conocidos
Para el equipo de la Universidad de Harvard, la E.coli recodificada puede tener todo tipo de usos industriales, y ser mejor en varias maneras, desde resistir a todos los virus hasta ser capaz de producir proteínas.
Las proteínas normales tienen 20 aminoácidos naturales como sus bloques de construcción. Pero la E.coli recodificada creará proteínas de hasta cuatro aminoácidos artificiales extra.
Crear un organismo resistente a los virus les da una gran ventaja, pero la E.coli recodificada no podrá crecer a menos que se alimente de esos aminoácidos artificiales, por lo tanto la bacteria no se extenderá en la naturaleza, la idea es contenerla.

El líder de la investigación, George Church, busca poder hacer animales de granja y células madre humanas que sean resistentes a todos los virus. Ese tipo de células podrían ser utilizadas para producir vacunas y para transplantes.
Como dice el investigador, es difícil hacer que las personas sean resistentes a los virus, al cáncer o al envejecimiento, pero sí se pueden crear órganos y tejidos para trasplantar que tengan esas propiedades.
El problema de su expansión
La principal preocupación que surge a raíz de esta investigación es que los microbios drásticamente modificados escapen de las fábricas o cambien sus genes con los microbios salvajes.
Al menos en teoría, el código genético cambiante de los microbios podría resolver estos problemas. En un gen que codifica una proteína, cada secuencia de tres letras del ADN especifica qué aminoácido se debe agregar a la cadena siguiente, o le dice a la maquinaria de fabricación de proteínas que se detenga cuando una proteína es completa.
El equipo de Church busca cumplir un proyecto todavía más ambicioso, cambiar los siete codones en la E.coli. Como eso requiere hacer más de 62.000 cambios en el ADN, no pueden hacerlo mediante la edición de genes.

Por eso diseñaron el genoma en un ordenador y luego la síntesis de ADN en piezas cortas con alrededor de 2000 letras de ADN de longitud. Esos segmentos cortos han sido cosidos juntos para hacer 87 segmentos más largos de 50.000 letras de ADN. El paso final será juntarlos para crear un genoma completo de E.coli de 4 millones de letras.
Sin embargo, antes deben comprobar que todos los genes funcionen, insertando los segmentos en una bacteria viva y borrando la secuencia equivalente.

Esta bacteria recodificada y resistente podría traer grandes avances para la medicina. En un futuro, otro gran desafío para Church será crear animales resistentes a los virus.
Otra de las ideas de Church y de otros biólogos, es recaudar dinero para lograr sintetizar el genoma humano por completo. A diferencia de las 4 millones de letras de la E. coli, el genoma humano tiene 6 billones de letras.
La creación de esta nueva forma de vida sin duda tendrá una gran repercusión en el campo de la ciencia.










